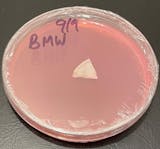
User picture

Pre-Poured Sterilized Malt Extract Agar Plates (10-Pack)
Pre-Poured Sterilized Malt Extract Agar Plates (10-Pack) is backordered and will ship as soon as it is back in stock.
Couldn't load pickup availability
Description
Description
Pre-Poured Sterilized Malt Extract Mushroom Agar Plates (10-Pack)
Freshly Poured Daily · Premium Nutrient Blend · Ideal for Mycelium Growth
Looking for the perfect agar plates for your fungal cultures? Our 10-Pack of Malt Extract Agar Plates is crafted fresh daily and formulated for high-performance mycelium development. Made from a carefully balanced blend of light malt extract, yeast extract, locust bean gum, and high-quality agar, these plates are the trusted choice for clean, consistent results.
Unlike plates that sit for weeks before shipping, ours are poured fresh in-house, sealed in polyolefin packaging, and shipped quickly to preserve potency. Perfect for mycologists, hobbyists, and lab techs who demand freshness and performance.
Key Features:
- 10 Pre-Poured Sterilized Malt Extract Agar Plates – Ready to use, right out of the box
- Perfect Blend for Mycelium Growth – Optimized mix of malt extract, yeast, and gum for strong, healthy cultures
- 100mm Polystyrene Petri Dishes – Durable and clear for easy observation
- Pressure Sterilized & Poured under laminar flow hood for purity
- Chloramphenicol Added to reduce contamination risks
- Store in the fridge, use within 3–4 weeks
- Assorted Plate Colors – Helps track production dates and adds a fun pop of color
Machine-Poured for Consistency & Precision
Starting April 2025, all agar plates are machine-poured in our clean room for unmatched consistency.
Our process includes:
- MediaPrep sterilization at 18 PSI for 30 minutes
- Cooling to 145°F, then precision-dispensing 25ml per plate
- UV-C sanitization, automatic capping, and laserjet labeling
This ensures every plate is uniform, sterile, and lab-ready.
Why Use Agar Plates in Mushroom Cultivation?
Agar has long been a staple in the mushroom-growing world. Here’s how it works:
Add a drop of spore solution, incubate for a few days, and you’ll see white mycelium patches form. Use this method to:
- Isolate the fastest, most vigorous strains
- Avoid contaminants by cutting away clean mycelium
- Transfer to spawn bags, jars, or liquid culture for further growth
Agar lets you control your genetics and improve your success rate—whether you're a seasoned pro or just getting started.
Read our Blog about using Agar by clicking Here
Watch video on using Agar and Agar Slants Here!